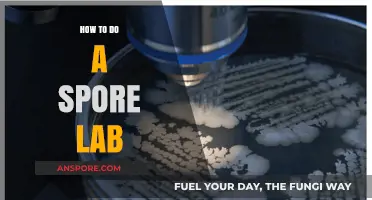
Mastering Spore Lab Techniques: A Step-by-Step Guide for Beginners

In *Spore’s* Tribal Stage, combat is a crucial mechanic for defending your tribe, expanding your territory, and acquiring food and resources. To engage in combat, you must first equip your tribe with weapons, which can be crafted using resources gathered from the environment. Weapons range from simple tools like rocks and bones to more advanced items like spears and torches, each offering different attack strengths and ranges. During battles, you control a single unit, typically your chieftain, while your tribe members fight autonomously. Success in combat relies on strategic positioning, timing attacks, and utilizing your tribe’s unique abilities, such as healing or summoning allies. Defeating rival tribes or epic creatures grants you access to their food and territory, helping your tribe grow and progress to the next stage of evolution. Mastering combat in the Tribal Stage is essential for survival and dominance in the game’s early phases.
Explore related products
$19.38 $35
$7.81 $18.99
What You'll Learn
- Mastering Melee Attacks: Use quick strikes, dodge, and exploit enemy weaknesses for efficient close combat
- Ranged Weapon Tactics: Aim for headshots, conserve ammo, and maintain distance to neutralize threats safely
- Team Coordination Strategies: Communicate roles, flank enemies, and protect healers for synchronized tribal victories
- Environmental Advantages: Use terrain, traps, and ambushes to outmaneuver and overpower opposing tribes
- Resource Management: Prioritize weapon upgrades, food, and health to sustain prolonged combat efforts effectively

Mastering Melee Attacks: Use quick strikes, dodge, and exploit enemy weaknesses for efficient close combat
In the Tribal Stage of Spore, melee combat is a dance of precision and timing. Quick strikes are your bread and butter—short, rapid attacks that minimize your exposure to counterattacks. Unlike slower, heavier blows, these strikes allow you to maintain momentum and pressure on your opponent. Aim for a rhythm of three to four quick jabs before disengaging, giving you enough offense to chip away at health while staying agile. This approach is particularly effective against larger creatures that rely on powerful but slow attacks, as it disrupts their ability to land a devastating hit.
Dodging is not just about avoiding damage; it’s about creating opportunities. In Spore’s Tribal Stage, dodging is a split-second decision that requires you to read your opponent’s movements. Watch for tells—like a creature rearing back or shifting its weight—and time your dodge to coincide with their attack animation. Practice makes perfect here: spend time observing enemy patterns in low-stakes encounters to refine your timing. A well-timed dodge not only avoids damage but also leaves your opponent momentarily vulnerable, giving you a window to counter with a quick strike.
Exploiting enemy weaknesses is the key to efficient combat. Every creature in the Tribal Stage has a weakness, whether it’s a slower attack speed, a predictable pattern, or a vulnerability to flanking. For example, creatures with long necks often have blind spots directly in front of them, making it easier to dodge their attacks and strike from the side. Similarly, creatures that rely on charging attacks can be outmaneuvered by staying mobile and striking during their recovery phase. Study your enemies, identify their weaknesses, and tailor your strategy to exploit them.
Combining these elements—quick strikes, dodging, and exploiting weaknesses—creates a combat style that’s both efficient and dynamic. Start by engaging with quick strikes to gauge your opponent’s reactions, then use dodges to avoid their counters and position yourself for a flank. Once you’ve identified their weakness, focus your attacks there to maximize damage. This methodical approach minimizes risk while maximizing reward, ensuring you emerge victorious with minimal health loss. Remember, in the Tribal Stage, survival isn’t just about strength—it’s about strategy.
Do Fern Spores Blow in the Wind? Unveiling Nature's Tiny Travelers
You may want to see also

Ranged Weapon Tactics: Aim for headshots, conserve ammo, and maintain distance to neutralize threats safely
In the tribal stage of Spore, ranged combat can be a game-changer, allowing you to engage enemies from a safe distance while minimizing risk. However, ammunition is often limited, and every shot must count. To maximize effectiveness, prioritize headshots. The head is a smaller target but offers a higher chance of critical damage, incapacitating foes quickly. Practice precision by aiming slightly above the target’s center mass, adjusting for projectile drop if using thrown weapons like spears or slings. This tactic not only conserves ammo but also reduces the number of shots needed to neutralize a threat.
Ammo conservation is critical in prolonged battles or when facing multiple enemies. Establish a mental count of your remaining projectiles and allocate them strategically. For instance, if you have five spears, use the first two to eliminate high-threat targets like predators, saving the last three for opportunistic strikes or defense. Avoid firing blindly; wait for clear shots when enemies are isolated or stationary. Additionally, learn to recognize enemy behaviors—some creatures charge, while others attack in groups. Use this knowledge to time your shots, ensuring each one lands with purpose.
Maintaining distance is the cornerstone of ranged combat safety. In Spore’s tribal stage, terrain can be your ally. Position yourself on elevated ground, such as hills or rocks, to increase visibility and create a natural barrier between you and enemies. If attacked, retreat in a zigzag pattern to avoid becoming an easy target. Keep an eye on your stamina bar, as sprinting depletes it quickly, leaving you vulnerable. Ideally, engage enemies from at least 20 in-game meters away, a distance that allows you to react to their movements while staying out of melee range.
Combining these tactics—headshots, ammo conservation, and distance maintenance—creates a synergistic approach to ranged combat. For example, when facing a pack of predators, start by targeting the alpha with a headshot to disrupt their formation. Follow up with calculated shots at stragglers, ensuring each spear or sling stone finds its mark. If ammunition runs low, disengage and lure enemies into traps or environmental hazards like water (if your creature can swim and theirs cannot). This methodical strategy turns ranged weapons into tools of precision, not just projectiles, ensuring survival in even the most hostile environments.
Spores vs. Sporophytes: Understanding the Key Differences in Plant Reproduction
You may want to see also

Team Coordination Strategies: Communicate roles, flank enemies, and protect healers for synchronized tribal victories
In tribal combat within Spore, victory often hinges on how well your team coordinates its efforts. Clear communication of roles is the cornerstone of this strategy. Assigning specific tasks—such as attackers, defenders, and healers—ensures that every member knows their purpose. For instance, designate one player as the primary healer, another as the tank to draw enemy fire, and the rest as flankers or damage dealers. This division minimizes chaos and maximizes efficiency, allowing your team to act as a cohesive unit rather than a disjointed group.
Flanking is a tactical maneuver that can turn the tide of battle in your favor. By splitting your team into smaller groups, you can attack enemies from multiple angles, disrupting their formation and overwhelming their defenses. For example, while the main group engages the enemy head-on, a smaller squad can circle around to strike from the rear or sides. This approach not only confuses the opposition but also reduces their ability to focus on a single target. However, timing is critical; coordinate the flank so that it coincides with the enemy’s moment of vulnerability, such as when they’re focused on your tank or healer.
Protecting healers is paramount to sustaining your team’s momentum. Healers are often the least armored and most vulnerable members, making them prime targets for enemies. Assign at least one defender to guard the healer at all times, ensuring they can operate without constant interruption. Additionally, position the healer in a safe but central location, allowing them to quickly respond to teammates in need while staying out of direct harm’s way. If the healer falls, your team’s ability to recover from damage diminishes significantly, increasing the likelihood of defeat.
Synchronized victories in tribal combat require practice and adaptability. Regularly debrief after battles to discuss what worked and what didn’t. For instance, if a flank failed due to poor timing, adjust your strategy to better coordinate the attack. Encourage open communication during battles, using simple, clear commands like “Flank left!” or “Protect the healer!” to keep everyone on the same page. Over time, this level of coordination will become second nature, transforming your team into a formidable force capable of outmaneuvering even the toughest opponents.
Do Mold Spores Grow? Understanding Their Survival and Spread
You may want to see also
Explore related products

Environmental Advantages: Use terrain, traps, and ambushes to outmaneuver and overpower opposing tribes
In the Tribal Stage of Spore, mastering the art of combat goes beyond brute force. The environment itself can become your greatest ally, offering opportunities to outsmart and overpower opposing tribes through strategic use of terrain, traps, and ambushes. By leveraging these environmental advantages, you can turn the battlefield into a deadly puzzle for your enemies.
Consider the terrain as your first line of defense. Elevated positions, such as hills or cliffs, provide a tactical edge by allowing your tribe to attack from higher ground. This not only increases your attack range but also forces enemies to climb, slowing their advance and exposing them to prolonged fire. Conversely, dense forests or narrow canyons can funnel opponents into choke points, where your tribe can concentrate its attacks. Always scout the map to identify these natural advantages and position your tribe accordingly.
Traps are another powerful tool for turning the environment against your foes. By placing traps in key areas—such as along narrow paths or near resource points—you can inflict damage or immobilize enemies before they even engage your tribe. Combine traps with terrain features for maximum effect: a well-placed trap at the base of a hill can decimate an enemy tribe as they struggle to ascend. Experiment with different trap types and placements to create a deadly gauntlet that wears down opponents before direct combat begins.
Ambushes are the pinnacle of environmental combat strategy. Use the terrain to conceal your tribe, waiting for the perfect moment to strike. For instance, hide in tall grass or behind rock formations, then launch a surprise attack when enemies are distracted or separated. Timing is crucial—wait until they’re engaged in gathering resources or divided into smaller groups. A successful ambush can cripple an opposing tribe, giving you the upper hand in the ensuing battle.
To maximize these environmental advantages, adopt a dynamic playstyle. Constantly assess the battlefield, adapting your strategy to exploit new opportunities. For example, if an enemy tribe focuses on a specific resource, set up traps and ambush points along their likely routes. Additionally, train your tribe members in ranged attacks to take full advantage of elevated positions and ambush tactics. By integrating terrain, traps, and ambushes into your combat strategy, you’ll transform the environment into a weapon, ensuring victory through cunning and preparation rather than sheer strength.
Can Plants Naturally Eliminate Mold Spores in Your Home?
You may want to see also

Resource Management: Prioritize weapon upgrades, food, and health to sustain prolonged combat efforts effectively
In the tribal stage of Spore, combat is a test of not just strength but also strategy, particularly in how you manage your resources. Weapon upgrades, food, and health are the trifecta that determines your tribe’s survival and dominance. Prioritizing these resources effectively can mean the difference between a swift victory and a humiliating defeat. For instance, investing too heavily in weapon upgrades early on might leave your tribe starving or vulnerable to injuries, while neglecting them can render you powerless against stronger enemies.
Let’s break it down step-by-step. First, weapon upgrades should be your initial focus, but only after securing a stable food source. Start by crafting basic weapons like spears or bows, which require minimal resources but provide a significant edge in early skirmishes. Once your food production is consistent—aim for at least 10 food per tribe member daily—allocate 30% of your resources to upgrading weapons. Advanced tools like the Epic Spear or Epic Bow not only deal more damage but also conserve stamina, allowing your tribe to fight longer without tiring.
Next, food is the backbone of your combat efforts. Prolonged battles deplete energy rapidly, and a hungry tribe is a weak tribe. Establish multiple food sources, such as hunting grounds and fruit trees, to ensure a steady supply. During combat, carry at least 20 food units per warrior to replenish health and stamina mid-fight. A practical tip: assign non-combatants to gather food while your warriors are away, ensuring your reserves never dwindle.
Health management is often overlooked but critical. Healing your tribe after battles prevents attrition and keeps your numbers strong. Always carry healing items like fruit or meat, and prioritize healing injured warriors immediately after a fight. A tribe with full health can engage in back-to-back battles without suffering long-term consequences. For example, if a warrior falls below 50% health, pull them out of combat to recover, even if it means temporarily reducing your fighting force.
Comparing these priorities, weapon upgrades offer immediate advantages but are unsustainable without food and health. Imagine a tribe with epic weapons but no food—they’ll collapse from exhaustion after a single battle. Conversely, a well-fed, healthy tribe with basic weapons can outlast opponents through attrition. The key is balance: allocate 30% of resources to weapons, 40% to food, and 30% to health, adjusting as needed based on your tribe’s size and combat frequency.
In conclusion, effective resource management in Spore’s tribal stage is a delicate dance. By prioritizing weapon upgrades, food, and health in a balanced manner, you ensure your tribe can sustain prolonged combat efforts without faltering. Remember, the strongest tribes aren’t just the ones with the best weapons—they’re the ones that know how to survive the fight.
How Do Ferns Reproduce? Unveiling the Mystery of Fern Spores
You may want to see also
Frequently asked questions
To initiate combat, approach an enemy tribe or creature and click on them. Your tribe will automatically engage in combat using their equipped tools or abilities.
Spears and torches are the most effective tools for combat. Spears deal more damage, while torches can set enemies on fire, causing additional damage over time.
Position your tribe members strategically, using terrain to your advantage. Keep weaker members away from the front lines and focus on attacking one enemy at a time to avoid being overwhelmed.
No, healing is not possible during combat in the Tribal Stage. Focus on defeating enemies quickly and retreat if your tribe takes too much damage. Heal afterward by resting at your nest.









![Tribal Warfare [DVD] [2018]](https://m.media-amazon.com/images/I/81GS6JlHMUL._AC_UY218_.jpg)